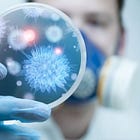
When Is Bioweapons Research Not Bioweapons Research?

Earlier this week, Senator Marco Rubio released a report chronicling his office’s multi-year investigation into the origins of the SARS-CoV-2 virus1.
When it was first released, I shared a link to the report on Notes, along with a simple question regarding the substance of the report:
Having had the opportunity to do a first pass at a deeper dive into the report, I can begin to answer that question—and unfortunately the answer is “Yes”. The report fails to address some key questions about the SARS-CoV-2 virus while providing relatively thorough documentation on others. It commits the cardinal reporting sin of obscuring some aspects of the larger narrative while overemphasizing other aspects.
The first thing we must acknowledge about the report is that it is, in its conception and execution, a political document serving a political agenda. It is focused on China to the exclusion of all else, and ultimately holds only China as culpable for the creation and lab release (accidental or otherwise) of the pathogen into the wider world2.
This report draws on numerous sources published in English and Chinese to examine the posture taken by the authorities of the People’s Republic of China (PRC) toward biosecurity, biosafety, and public health starting from 2018 until 2021. Its primary focus is on tracing the authorities’ response to the emergence of SARS-CoV-2, the virus that causes COVID-19, as it progressed from a localized outbreak to a national epidemic to a full-fledged pandemic.
To be clear, China’s role in the spread of COVID-19 can be identified and, at least in Marco Rubio’s eyes, shown to be a deciding factor in the emergence of COVID-19 as a new global “pandemic”. However, China is not the whole of the story. More on that later.
Senator Rubio made a clear choice to focus exclusively on China for his investigation into the origins of COVID-19 and the SARS-CoV-2 virus. We can see this plainly in the framing questions he uses to set up the narrative arc of the report3:
The following questions served as the frame of reference for this report:
• Prior to the pandemic, were biosafety conditions at laboratories studying bat
coronaviruses in Wuhan subpar and potentially dangerous? If so, were the
managers of these labs aware of such problems?
• Were senior leaders in the ruling CCP and PRC government concerned about
biosecurity and biosafety as general matters, and/or particularly concerned about
the biosafety conditions at laboratories studying bat coronaviruses in Wuhan?
• Is there evidence that a laboratory incident occurred in Wuhan concurrent with
the initial outbreak of SARS-CoV-2 in 2019?
• When did the CCP leadership at the local and central levels first become aware
that there was an outbreak of infectious disease? Did they know it was caused by
a novel pathogen? If so, did they suspect a zoonotic spillover or a laboratory
incident was most likely responsible for that outbreak?
Straightaway we can see that Senator Rubio, for better or worse, is explicitly targeting China’s role in the emergence and spread of the SARS-CoV-2 virus worldwide, and thus in China in particular.
In particular, Rubio calls China out for their lack of transparency regarding the information they possess(ed) about the SARS-CoV-2 virus.
Awareness of a laboratory incident seemed to have shaped the CCP leadership’s response to SARS-CoV-2: a response characterized by strict controls of information, obfuscation, misdirection, punishment of whistleblowers, and the destruction of key clinical evidence. A closer look at the early days of the pandemic revealed that even when Beijing shared information with the international community – such as the initial notice of a pneumonia outbreak, the later admission that a novel coronavirus was its causal agent, and the publishing of its genomic sequence – it did so belatedly. In all three cases, Beijing possessed the relevant information for some time before sharing it, and disclosed it only when compelled to do so by circumstances beyond its control.
However, while Senator Rubio does go on to present his case for asserting this, in the process he overlooks the demonstrable failures of corporate media in the West and in the United States especially to adequately report on the emergence of the virus in late December 2019 and early January 2020.
Yet the legacy media has been tardy if not downright derelict in covering several significant aspects of this ongoing event. It was alternative media and social media that first called attention to the existence of the virus, officially named 2019-nCoV (also referenced as nCoV2019). It has been the alternative media and social media that has highlighted serious shortcomings and outright deceptions by Chinese officials and the state-run media.
China’s success in being less than transparent with what it knew and knows about the SARS-CoV-2 virus has without a doubt been facilitated by the multiple failures of corporate media to adequately report on the earliest days of the global outbreak.
The Rubio report also takes great pains to lay a conceptual foundation for the chronology of events it advances, by discussion and documenting China’s efforts in “biosecurity” and “biosafety”.
A key concept discussed in this report is shengwu anquan (生物安全), a Chinese term that can encompass, depending on the context in which it is used, what is commonly meant by the two English terms “biosecurity” and “biosafety.”
However, the report omits an important context by acknowledging the extent to which these issues are a priority among Western nations, and (again) in the United States especially.
There is no mention in the report of the Nunn-Lugar programs in biological “threat reduction” which came about in the 1990s and is a forerunner of today’s biosecurity infrastructure.
Ultimately, the distinction between what constitutes “bioweapons research” versus “threat reduction research” is a rather Clintonian parsing of the terms.
Regardless of the terms, the research activities involved target dangerous pathogens. Regardless of the terms, the research demands the storage of dangerous pathogens. Regardless of the terms, the research invites if not demands the strictest of scrutiny to ensure it remains within the parameters of the BWC.
Moreover, regardless of the requirements of the BWC, it is a proven fact that virtually all nations conduct research involving dangerous pathogens. Russia certainly does, and the COVID pandemic is absolute proof that China does as well—and COVID is, like the Ames anthrax strain, a grim reminder how easy it is for threat reduction to become threat creation.
This much is certain: once a dangerous pathogen escapes the confines of the lab, the matter of bioweapons research versus threat reduction research quickly becomes a distinction without a difference.
From these dubious origins within 1990s programs to address disposing of the former Soviet Union’s stockpiles of weapons of mass destruction comes nearly the whole of the US biosecurity infrastructure, which has evolved and expanded greatly beyond its Nunn-Lugar origins4. However, even the more recent lineages of the US biosecurity infrastructure are missing from Rubio’s report—there is no mention of the US DoD Biological Threat Reduction Program or the Department of State’s BioSecurity Engagement Program.
This evolution of Western and US biosecurity initiatives is crucial to understanding even China’s biosecurity efforts, for it is here that we begin to see names and entities that play a recurring role in establishing even just the China chronology:
It was Kadlec who formed the Bipartisan Commission on Biodefense in 2014 and began the planning of his Manhattan Project in earnest. Those involved with him in this commission included Tom Ridge, the first Homeland Security Secretary, Donna Shalala, a former Health and Human Services (HHS) Secretary, Dr Margaret Hamburg, a former Food and Drug Administration (FDA) commissioner, Scooter Libby, formerly of Project for a New American Century (PNAC), William Karesh, the vice president of EcoHealth Alliance and an adviser to the WHO on reforms to the International Health Regulations (IHR), and Kenneth Wainstein, now the Under Secretary of Homeland Security for Intelligence and Analysis.
EcoHealth Alliance, of course, would also figure prominently in multiple research initatives within China and within the Wuhan Institute of Virology dating back to the mid 2010s if not sooner. EcoHealth was able to become a player in China’s “biosecurity” and “biosafety” initiatives because it was built up as a player in these sort of programs by the US programs first.
Where the Rubio report is strongest is in laying out a fairly comprehensive chronology of Chinese biosecurity research initiatives going back a few years before the initial 2019 outbreaks in Wuhan. China’s intensive research into bat coronavirus is fairly well documented here.
Regretably, Senator Rubio fails to acknowledge that much of the original research work into China’s bat coronavirus projects was first done by alternative media site ZeroHedge. This is a shame, for Rubio’s report serves as yet more corroboration of ZeroHedge’s early reporting on the potential lab connections and possible lab origins of the SARS-CoV-2 virus.
This interest in the truth about the CCPVirus' origins would get ZeroHedge falsely accused by BuzzFeed and then subsequently banned from Twitter, but their journalism has withstood the test of time--researchers at the Wuhan Institute of Virology had not only studied bat coronaviruses for some time, but were actively seeking graduate students to participate in that research as late as December, 2019.
Thus, while the report is strongest on the chronology of Chinese policies and actions surrounding the Wuhan Institute of Virology, that chronology also serves to highlight a fundamental flaw in the report—it is not at all the groundbreaking report Rubio claims it to be.
The office of U.S. Senator Marco Rubio (R-FL) released a groundbreaking new report on the origins of the Covid-19 pandemic. Titled “A Complex and Grave Situation,” the report is a 328-page political chronology of the SARS-COV-2 outbreak.
The report does present considerable evidence outlining the documented and potential connections between the WIV and SARS-CoV-2. However, it ultimately is a retread, covering ground numerous other commentators (including myself) have already covered.
Much of China’s mendacity in late 2019 and early 2020 has already been reported and established—which mendacity goes a long way towards supporting a thesis that, whether or not China weaponized the virus itself, China absolutely weaponized the global outbreak which followed.
While China quite naturally denies any culpability by the Wuhan Institute for either the genesis of the CCPVirus or its release into the world, their denials are fundamentally tainted by one unalterable truth: they are actively concealing as much information about the CCPVirus and its origins as they can.
The WHO states China is refusing to allow the WHO to participate in China's own internal investigation into the origins of the CCPVirus.
China has been deleting all online research on the CCPVirus and its origins.
At a time when China was still denying human-to-human transmission, Chinese firms were literally stripping all the medical supplies from other nations that they could, buying them by the ton and shipping them back to China.
China knew of human-to-human transmission of CCPVirus for at least six days in January while still professing to the WHO that there was "no evidence" of this (for its part, the WHO was informed of this by Taiwan in December and ignored the warning in favor of China's false statements on this issue).
In mid February, China issued a "wartime order" to put a stop to "lab leakage" of deadly pathogens.
In mid February, China dispatched Chen Wei, the nation's top biochemical weapons defense expert, to take control of the BSL4 (P4) lab at the Wuhan Institute.
On February 10 or 11, China arrested citizen journalists Fang Bin and Chen Quishi for attempting to report on the CCPVirus outbreak in Wuhan.
In a speech President Xi Jinping gave to party leaders on February 3, he acknowledged having been apprised of the severity of the outbreak in early January, weeks before disclosing this to the world.
China ignored its own "state of the art" warning system for emerging pandemic pathogens.
China forbade researchers in early January from publicly discussing CCPVirus.
China ordered labs to destroy their biological samples and stop all research into the CCPVirus in December.
China suppressed for over two weeks data indicating an outbreak of a SARS-like pathogen obtained in late December, 2019.
China systematically undercounted and hid CCPVirus cases from the world.
Nor should the world ever forget the tragic case of Li Wenliang, who on December 30 attempted to warn the world about the CCPVirus, only to be silenced and humiliated by the Chinese government. Dr. Li would die from the virus on February 6.
For the report to largely rehash materials already established makes it a bit of a disappointment—it is a comprehensive overview of the chronology of COVID as it pertains to China, but it completely ignores other elements at least as crucial.
Nowhere, for example, does the body of the report mention Anthony Fauci (Fauci’s name does appear in a single endnote), who as head of the National Institutes’ of Health National Institute of Allergies and Infectious Diseases (NIAID), helped steer federal grant dollars through EcoHealth Alliance to the Wuhan Insititute of Virology.
Leaked documents have contradicted Fauci numerous times, and it is now clearly established that the research at Wuhan did involve gain-of-function research.
Dr. Anthony Fauci was absolutely adamant that the National Institutes of Health has never funded dangerous research on bat viruses in the Chinese lab suspected of being the source of the COVID-19 pandemic, when he was questioned by Republican Sen. Rand Paul two weeks ago.
“Senator Paul, with all due respect, you are entirely and completely incorrect that the NIH has not ever and does not now fund ‘gain of function’ research in the Wuhan Institute of Virology,” Fauci said in the fiery Senate hearing on May 11.
He couldn’t have been more certain.
Until he wasn’t certain a few hours later.
That very afternoon, Fauci admitted to “a very minor collaboration as part of a subcontract of a grant we had a collaboration with some Chinese scientists,” during an appearance at Poynter.org’s “festival of fact checking.”
It’s like being a little bit pregnant. The NIH either funded so-called gain-of-function research to juice up bat coronaviruses in China, or it didn’t. Turns out it did. And it did it by exploiting a loophole in an Obama-administration ban on the Frankenstein research put in place in 2014.
Nor is Fauci’s role in the contrived paper “The Proximal Origin of SARS-CoV-25” even acknowledged, much less explored. This paper was a significant effort to deny a laboratory origin of the SARS-CoV-2 virus, thereby exonerating the WIV from any culpability in its emergence.
SARS-CoV-2 is the seventh coronavirus known to infect humans; SARS-CoV, MERS-CoV and SARS-CoV-2 can cause severe disease, whereas HKU1, NL63, OC43 and 229E are associated with mild symptoms6. Here we review what can be deduced about the origin of SARS-CoV-2 from comparative analysis of genomic data. We offer a perspective on the notable features of the SARS-CoV-2 genome and discuss scenarios by which they could have arisen. Our analyses clearly show that SARS-CoV-2 is not a laboratory construct or a purposefully manipulated virus.
For Senator Rubio to argue SARS-CoV-2 emerged at the Wuhan Institute of Virology while ignoring Anthony Fauci’s documented efforts to discredit that very thesis is a curious and disappointing choice.
Prevailing academic standards for authorship required Fauci's role be acknowledged. This did not happen. Moreover, the paper's authors privately shared their suspicions the virus was in fact a lab construct.
Did Anthony Fauci participate in a scientific fraud? There is at least some evidence to suggest he did.
Fauci’s only appearance in the Rubio report is in an endnote capturing a statement by him downplaying the potential for asymptomatic transmission:
In all the history of respiratory-borne viruses of any type, asymptomatic transmission has never been the driver of outbreaks. … Even if there’s a rare asymptomatic person that might transmit, an epidemic is not driven by asymptomatic carriers.
Fauci’s complete comment on this point appeared in a press briefing on January 28, 2020, and is available on YouTube here.
Again, Rubio’s disregard of Fauci’s comments in this regard are a curious omission, as the report itself argues that China’s downplaying of asymptomatic transmission was a significant event in the overall chronology:
Despite this evidence, PRC authorities continued to discount asymptomatic transmission, and Beijing’s resistance to acknowledging the role played by asymptomatic transmission was, with great consequence, echoed elsewhere as other countries began to confront the pandemic. One recent study estimated that more than one-third of SARS-CoV-2 infections are asymptomatic, and when pre-symptomatic cases are included, silent infections rise to as much as 42.8 percent of all infections. Another recent comparison of household studies confirmed that individuals with asymptomatic infections transmitted SARS-CoV-2 to close contacts, although to a somewhat lesser extent than those with symptomatic infections.
At a minimum, Fauci’s statement of January 28, 2020, is a prime exemplar of the “great consequence” Rubio attributes to a Chinese effort to discount asymptomatic transmission. To bury this detail in an endnote ends up a curious whitewashing of Fauci’s own documented role in the global COVID-19 outbreak and the government policies which emerged in response. This statement deserved more visibility in the report than it received.
Separately, while the Rubio report does mention Peter Daszak, of the EcoHealth Alliance, Daszak’s role in attempting to squelch the “lab leak hypothesis” is treated almost dismissively:
Peter Daszak of the EcoHealth Alliance, a longtime WIV collaborator who resorted to a variety of shenanigans to squelch discussion of the lab leak theory once the pandemic began, gave at least three interviews in which he claimed that the WIV had not fully sequenced the sample until January 2020 when its similarity to SARS-CoV-2 was noticed and it was pulled out of a freezer for closer examination. Daszak told Wired in February 2020, “At the time [it was originally collected], we were looking for Sars-related viruses, and this one was 20 percent different. We thought it’s interesting, but not high-risk. So we didn’t do anything about it and put it in the freezer.” He repeated the same story to the New York Times Magazine in April. In July, Daszak told the Sunday Times that there was no significance in the renaming (and the failure to disclose the renaming) and called those who raised questions about the matter “the conspiracy folks.”
What the report does not mention is that said “shenanigans” included organizing a “letter of support” by multiple researchers in February of 2020 condemning the already rising theories of a lab origin for SARS-CoV-2, insisting that on a zoonotic origin for the virus6.
We stand together to strongly condemn conspiracy theories suggesting that COVID-19 does not have a natural origin. Scientists from multiple countries have published and analysed genomes of the causative agent, severe acute respiratory syndrome coronavirus 2 (SARS-CoV-2), and they overwhelmingly conclude that this coronavirus originated in wildlife, as have so many other emerging pathogens.
So ham-handed was this effort that the Lancet would later be forced to publish a “clarification7” in June of 2021 acknowledging Peter Dasak’s obvious conflict of interest.
In February, 2020, 27 public health experts co-authored a Correspondence in The Lancet (“Statement in support of the scientists, public health professionals, and medical professionals of China combatting COVID-19”), supporting health professionals and physicians in China during the early stages of the COVID-19 pandemic. In this letter, the authors declared no competing interests. Some readers have questioned the validity of this disclosure, particularly as it relates to one of the authors, Peter Daszak. In line with guidance from the International Committee of Medical Journal Editors, medical journals ask authors to report financial and non-financial relationships that may be relevant to interpreting the content of their manuscript. There may be differences in opinion as to what constitutes a competing interest. Transparent reporting allows readers to make judgments about these interests. Readers, in turn, have their own interests that could influence their evaluation of the work in question. With these facts in mind, The Lancet invited the 27 authors of the letter to re-evaluate their competing interests. Peter Daszak has expanded on his disclosure statements for three pieces relating to COVID-19 that he co-authored or contributed to in The Lancet—the February, 2020, Correspondence, as well as a Commission Statement and a Comment for the Lancet COVID-19 Commission
The addendum was a point of some humiliation for the medical journal.
This particular “shenanigan” was pivotal in China’s sustaining the narrative on the zoonotic origin of the SARS-CoV-2 virus, which makes Rubio’s silence on the topic curious at the very least, and arguably mendacious.
Similarly, Ralph Baric, of the University of North Carolina Chapel Hill, appears in the body of the report only once (but is mentioned four more times in the endnotes), in conjunction with Peter Daszak’s proposal for Project DEFUSE.
This, too, is a curious omission, as Ralph Baric’s name emerges routinely in multiple investigative efforts into the origin of SARS-CoV-2, such as Igor Chudov’s connecting of many dots in support of the thesis that Project DEFUSE in fact moved forward and that SARS-CoV-2 was the result of that effort, thanks in no small part to the efforts of Ralph Baric.
Project DEFUSE tested the result in transgenic (humanized) mice, having human ACE2 receptors in their lungs. The mice had to be humanized: as we know, Sars-Cov-2 was able to infect people, but not wild mice, at the beginning of its history. (Side Note: Later on, another famous virologist, Ralph Baric of UNC, worked on allowing Sars-Cov-2 to infect regular — not transgenic — mice. And guess what, somehow the later variants of Sars-Cov2 (Omicron) do infect mice, a development that may or may not be related to Baric’s research. Baric was also on the email thread with Fauci shown above.).
Far from being a “groundbreaking” report, the Rubio report is, in the end, merely a reasonably thorough and documented treatment of China’s role in the origin of the SARS-CoV-2 virus. It stands as a reminder that the Wuhan Institute of Virology was hardly a bit player in this strange and still-unfolding psychodrama, but it does so at the expense of the much larger narrative surrounding SARS-CoV-2, a narrative which not merely invites but demands investigation and inquiry of the US National Institutes of Health as well as the whole of the international biosecurity/biosafety apparatus.
As we have seen with the Faucists’ constant obsession with playing God with viruses, biosecurity and biosafety are a true globalist enterprise.
Sadly but not surprisingly, we now know that Boston University was not the only research facility playing mix-n-match genes with variants of the SARS-CoV-2 virus.
Imperial College London has also been engaging in recreational “research” by splicing spike proteins from either the Omicron or Delta variants of the virus onto the original Wuhan strain.
China is a player in this, but only because the NIH, NIAID, BTRP, BEP, DTRA, EcoHealth, Peter Daszak, Ralph Baric, and Anthony Fauci are also players in this. Arguably, China’s role is less significant in the wider corruption demonstrably on display than that of Pfizer, whose cynical and company-wide attitudes towards pharmaceutical regulation typifies everything that is wrong with Western medical establishments today.
Note: Pfizer is also not mentioned in the Rubio report.
By not paying even perfunctory lip service to these other important threads in an extremely complex narrative, the Rubio report presents a very one-sided and thus inaccurate depiction of the origins of the SARS-CoV-2 virus. By focusing on China’s role to the virtual exclusion of all else, Senator Rubio presents an inference that there are no other significant actors involved, no other sinister roles to be played—a stance that is very much at odds with what has already been amply documented regarding the SARS-CoV-2 virus’ origins.
Is the Rubio report a whitewash of the COVID pandemic or is it an important truth telling?
Ultimately, it is an injudicious mixture of both, which renders the report a dubious, deceptive, and highly problematic perspective on the China aspects of COVID “pandemic”.
Senator Rubio, Marco. “A Complex And Grave Situation: A Political Chronology Of The SARS-CoV-2 Outbreak”. Marco Rubio, US Senator For Florida. May 17, 2023. Available online at https://www.rubio.senate.gov/public/_cache/files/4f6bb786-504e-443d-8904-974dafc1cd0e/CD3BC3317D197A25E9FF01EBFB869357.rubio-covid-origins-report-final.pdf
Ibid.
Ibid.
Policy and Global Affairs Committee on International Security and Arms Control , and Committee on Enhancing Global Health Security through International Biosecurity and Health Engagement Programs. “The History of Cooperative Threat Reduction (1991-2018).” A Strategic Vision for Biological Threat Reduction, National Academies Press, 2020. Available online at https://www.ncbi.nlm.nih.gov/books/NBK557949/
Andersen, Kristian G et al. “The proximal origin of SARS-CoV-2.” Nature medicine vol. 26,4 (2020): 450-452. doi:10.1038/s41591-020-0820-9
Calisher, Charles et al. “Statement in support of the scientists, public health professionals, and medical professionals of China combatting COVID-19.” Lancet (London, England) vol. 395,10226 (2020): e42-e43. doi:10.1016/S0140-6736(20)30418-9
Editors Of The Lancet. “Addendum: Competing Interests and the Origins of SARS-CoV-2.” The Lancet, vol. 397, no. 10293, 2021, pp. 2449–50.